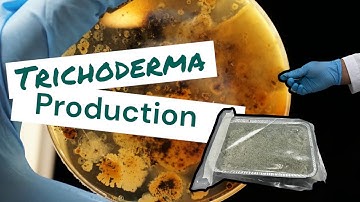
How to produce Trichoderma ?! Learn with us

⬇ DOWNLOAD NOW
Kalau muncul iklan pop-up, tutup lalu klik tombol kembali
Download lagu Trichoderma production in lab | grafting garden secara gratis hanya untuk keperluan promosi. Dukung artis favorit kamu dengan membeli musik original di iTunes atau platform resmi lainnya.
How to produce Trichoderma ?! Learn with us
How to produce Trichoderma ?! Learn with us
 How to grow the culture of Trichoderma Harzianum in lab ||Preparation || Microorganisms ||kill pests
How to grow the culture of Trichoderma Harzianum in lab ||Preparation || Microorganisms ||kill pests
 Trichoderma Production
Trichoderma Production
 5 UNIQUE Ways of using Trichoderma Bio-fungicide in Garden | How to Multiply Trichoderma Viride?
5 UNIQUE Ways of using Trichoderma Bio-fungicide in Garden | How to Multiply Trichoderma Viride?
 How to Use Trichoderma That You Never Know
How to Use Trichoderma That You Never Know
 Trichoderma viride... inoculation into Potato Dextrose Broth for Mass multiplication
Trichoderma viride... inoculation into Potato Dextrose Broth for Mass multiplication
 #short video#video# Trichodarma Lab Material
#short video#video# Trichodarma Lab Material
 Plant grafting technique for beginners successful and satisfying #usa #grafting #videos
Plant grafting technique for beginners successful and satisfying #usa #grafting #videos